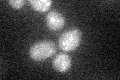
YAR028W
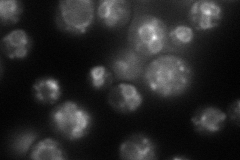
YAR028W
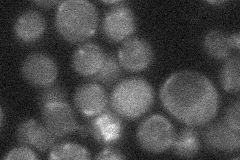
YAR028W
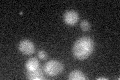
YAR028W

View description
Putative integral membrane protein, member of DUP240 gene family; GFP-fusion protein is induced in response to the DNA-damaging agent MMS
Localization:
Intensity:
Fold change:
Significance:
-
C’ GFP library in SD
ambiguous21.29 -
N' NOP1pr-GFP in SD
punctate,vacuole membrane82.1405 -
N' TEF2pr-mCherry in SD

vacuole membrane171.917 -
N' NATIVEpr-GFP in SD
below threshold17.1179 -
N' TEF2pr-VC and Cyto-VN in SD

punctate36.2938 -
C’ GFP library in SD+DTT

ambiguous19.960.93No -
C’ GFP library in SD+H2O2

ambiguous20.630.96No -
C’ GFP library in Starvation Media
ambiguous23.121.08No -
C’ GFP library on the background of Pup2-DaMP

ambiguous -
C’ GFP library on the background of CCT mutant

ambiguous17.72480.831962No
